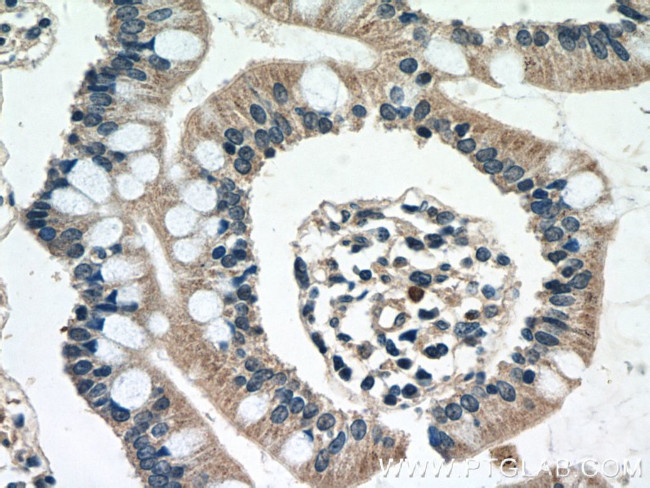
DEFB121 Antibody in Immunohistochemistry (Paraffin) (IHC (P))

Search
Proteintech
DEFB121 Polyclonal Antibody
{{$productOrderCtrl.translations['antibody.pdp.commerceCard.promotion.promotions']}}
{{$productOrderCtrl.translations['antibody.pdp.commerceCard.promotion.viewpromo']}}
{{$productOrderCtrl.translations['antibody.pdp.commerceCard.promotion.promocode']}}: {{promo.promoCode}} {{promo.promoTitle}} {{promo.promoDescription}}. {{$productOrderCtrl.translations['antibody.pdp.commerceCard.promotion.learnmore']}}
产品信息
25761-1-AP
种属反应
宿主/亚型
分类
类型
抗原
偶联物
形式
浓度
规格
纯化类型
保存液
内含物
保存条件
运输条件
产品详细信息
Immunogen sequence: VTPVMKCWG KSGRCRTTCK ESEVYYILCK TEAKCCVDPK YVPVKPKLTD TNTSLESTSA V (17-76 aa encoded by BC130609)
靶标信息
Beta-defensins (also designated BDs, or hBDs in human) are small cationic peptides with broad-spectrum antimicrobial activity against a variety of enveloped viruses, fungi and bacteria. Produced in mucosal epithelia and neutrophils of several species, beta-defensins are developmentally regulated. The family of beta-defensin proteins share a common defensin-motif that is characterized by multiple cysteine residues and a highly conserved tertiary structure. Besides playing a significant role in host immune defense, many beta-defensins also are involved in sperm maturation and capacitation. beta-defensin 121 is a 76 amino acid secreted protein that most likely contains a signal peptide sequence that requires cleavage by proteolytic enzymes in order to become biologically active. While expressed at low levels in testis, beta-defensin 121 is abundantly expressed in epididymal caput and corpus and, unlike other beta-defensins, it does not appear to be regulated by androgens.
仅用于科研。不用于诊断过程。未经明确授权不得转售。
篇参考文献 (0)
生物信息学
蛋白别名: Beta-defensin 121; Beta-defensin 21; DB121; DEFB-21; Defensin, beta 121; defensin, beta 21; epididymis secretory sperm binding protein
基因别名: DEFB121; DEFB21; ESC42RELC
UniProt ID: (Human) Q5J5C9
Entrez Gene ID: (Human) 245934